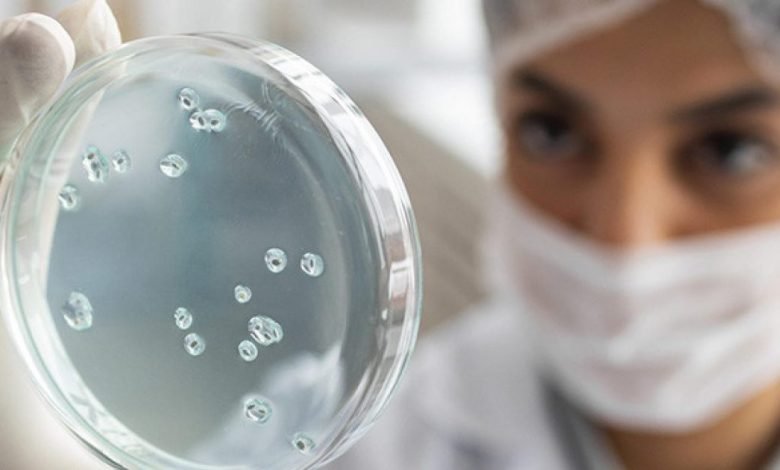

MACEIÓ – Dia Nacional do Infectologista: profissionais que combatem doenças infecciosas ganham destaque no Dia 11 de abril.
Entre as enfermidades mais comuns que requerem a atuação do infectologista estão a tuberculose, hepatites, hanseníase, leishmaniose, esporotricose e infecções sexualmente transmissíveis, como HIV/Aids. Essas doenças demandam cuidados especializados para garantir a plena recuperação e o bem-estar dos pacientes.
Neste dia especial, a Saúde de Maceió destaca a importância do trabalho desses profissionais no combate a enfermidades complexas que podem levar a complicações graves e até mesmo ao óbito. Segundo o infectologista Renee Oliveira, as doenças tratadas por essa especialidade podem ter impactos significativos na saúde das pessoas, exigindo atenção e cuidados específicos.
O Dr. Oliveira ressalta que os microorganismos presentes no corpo humano nem sempre causam danos à saúde, mas eventos específicos podem favorecer o desenvolvimento de doenças infectocontagiosas, como sífilis, HIV/Aids e até a Covid-19, quadros que podem evoluir para problemas graves de saúde.
O profissional destaca a ampla abrangência de atuação da infectologia, que engloba desde pesquisas sobre imunização até o controle e prevenção de infecções hospitalares. Além disso, a presença do infectologista é essencial em casos de indivíduos imunossuprimidos ou com maior risco de infecções, bem como na elaboração de protocolos para a prevenção de doenças infecciosas.
Em Maceió, o atendimento especializado em infectologia é oferecido no Pam Salgadinho, que cuida especialmente de pacientes com Infecções Sexualmente Transmissíveis, sendo o HIV/Aids a maior demanda da capital para esse tipo de atendimento.
O Dia Nacional do Infectologista, comemorado em 11 de abril em homenagem ao nascimento de Emílio Ribas, reconhecido pioneiro na área das doenças infecciosas no Brasil, destaca a importância deste profissional, especialmente durante a pandemia de Covid-19. A presença do infectologista foi fundamental para a compreensão e combate mais eficaz do vírus Sars-CoV-2.
Assim, os infectologistas desempenham um papel crucial na promoção da saúde da população, atuando na linha de frente contra doenças infecciosas e garantindo a segurança e bem-estar dos pacientes.



